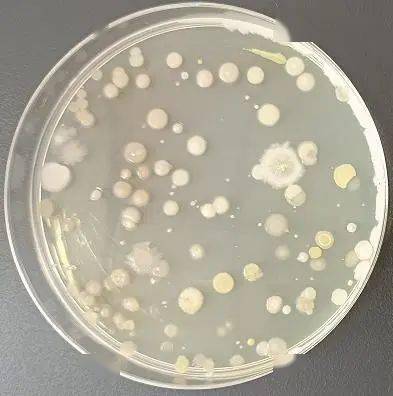
支援协作民盟西城区委为对口帮扶村联系免费土壤检测助力乡村振兴

需氧菌

请大神们帮忙看一下平板菌的生长情况
图片尺寸507x900
重庆食药监公布5批次不合格产品涉及丑桔桶装水合川桃片
图片尺寸573x568
包图网提供精美好看的需氧菌细胞病原体示例图素材免
图片尺寸700x473
药品需氧菌总数菌落有点奇怪 - 食品微生物检测
图片尺寸1080x1440
需氧菌加快堆肥 - buy microbes for faster composti
图片尺寸768x1024
阴道微生态与宫颈癌到底有什么关系一次全说清楚
图片尺寸1080x1548
食品与环境检测
图片尺寸742x489
那吃不完的西瓜咋办啊?
图片尺寸1080x570
呈螺旋形或弧形弯曲状的微需氧菌,也是第一个被正式
图片尺寸570x352
深入认识水中隐患铜绿假单胞菌,立升净水器为你的饮水健康保驾护航!
图片尺寸500x495
肠道有害菌
图片尺寸640x480
微生物限度里需氧菌指的是什么
图片尺寸600x435
图说| 需氧菌 vs 厌氧菌
图片尺寸640x4480
非发酵革兰阴性杆菌2012ppt
图片尺寸1080x810
阴道微生态与宫颈癌到底有什么关系?一次全说清楚
图片尺寸704x480
关于需氧菌培养拭子你需要了解的一切
图片尺寸1024x682
支援协作民盟西城区委为对口帮扶村联系免费土壤检测助力乡村振兴
图片尺寸393x396
牙疼不是病他住icu两个月才保住性命
图片尺寸320x240
g 需氧菌及兼性厌氧菌:乳杆菌,非溶血性链球菌
图片尺寸1200x800
什么是败血症?有什么表现,来了解一下吧
图片尺寸550x309